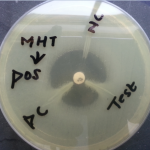
Modified Hodge test Positive

Collection Group: Clinical Bacteriology
Hodge Test Positive: Introduction, Principle, Procedure and Result Interpretation
Modified Hodge Test positive Modified Hodge Test (MHT) is a...
Modified Hodge Test positive Modified Hodge Test (MHT) is a...
D Zone Test: Introduction, Test Procedure and Clinical Significance
 Introduction of D-Zone Test This test is most important in Staphylococcus...
Introduction of D-Zone Test This test is most important in Staphylococcus...
Biochemical Test Reaction Interpretation of Gram Negative Bacterium: TSI, SIM, Citrate Utilization and Urea Hydrolization Test
 Biochemical Test Reaction for Gram-Negative Bacilli or Rods The most...
Biochemical Test Reaction for Gram-Negative Bacilli or Rods The most...
